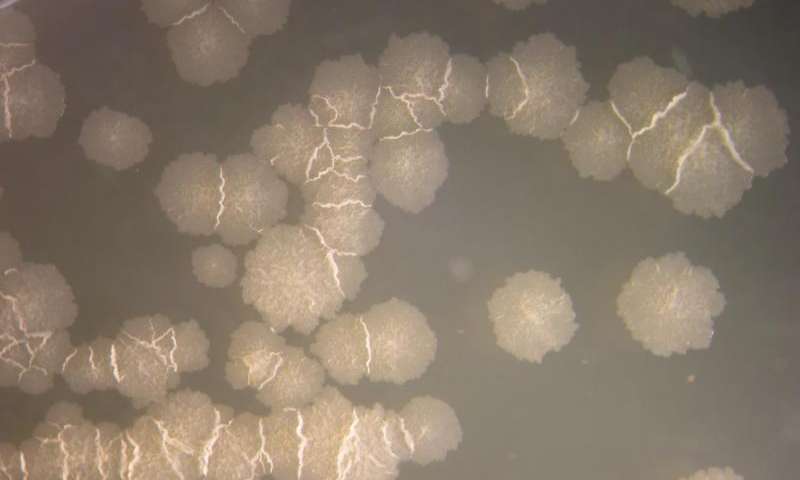

Immagine: Mycobacterium tuberculosis è l’agente eziologico della tubercolosi. Credit: IMM / UZH
Più veloce la rilevazione di agenti patogeni nei polmoni !
Ciò che prima richiedeva diverse settimane è ora possibile in due giorni: grazie ai nuovi metodi molecolari gli agenti patogeni da micobatteri che causano infezioni polmonari o la tubercolosi, possono essere rilevati molto più rapidamente. In termini di tempo, le colture batteriche non hanno più bisogno di essere prelevate dai campioni dei pazienti, il che significa che una terapia adeguata può essere avviata rapidamente.
I micobatteri sono la causa di varie malattie.
i Mycobacterium tuberculosis, il principale rappresentante di questo genere, è l’agente eziologico della tubercolosi che ha ucciso circa 1,5 milioni di persone in tutto il mondo nel 2014. I micobatteri non tubercolari possono scatenare infezioni polmonari, infezioni linfonodali e malattie della pelle nei pazienti con sistema immunitario compromesso. A causa di un numero sempre maggiore di persone con malattie polmonari croniche, queste infezioni difficili da trattare, sono in aumento continuo negli ultimi decenni.
( Vedi anche:Sviluppato nuovo vaccino contro la tubercolosi).
Pochi giorni per rilevare gli agenti patogeni invece di diverse settimane
Un gruppo di ricerca dell’ Istituto di Microbiologia presso l’Università di Zurigo e il Centro Nazionale per micobatteri, ha utilizzato uno studio su larga scala con più di 6.800 campioni prelevati dai pazienti, per testare metodi molecolari-based per il rilevamento di agenti patogeni. Poiché molti micobatteri crescono a un ritmo molto lento, il rilevamento di routine che utilizza colture di batteri nei laboratori, impiega diverse settimane per essere completato. Il test di sensibilità successiva per determinare il trattamento appropriato, richiede circa una o due settimane.
“Per i pazienti e medici, questo lungo periodo di attesa è eccessivo”, dice il Dr. Peter Keller dell’ Istituto di Microbiologia Medica alla UZH. “In confronto, con i metodi di rilevazione molecolare, la maggior parte dei pazienti riescono a sapere dopo uno o due giorni se hanno una infezione da agenti patogeni della tubercolosi o da micobatteri non tubercolari”.
Per il loro studio, i ricercatori hanno sviluppato un algoritmo diagnostico per rilevare micobatteri direttamente dal campione del paziente utilizzando l’analisi genetica. Con questo metodo di rilevazione molecolare ultra-veloce, i campioni dei pazienti sono stati esaminati nell’arco di tre anni e confrontati con i risultati delle colture batteriche di più 3.000 pazienti. I nuovi metodi molecolari sono risultati accurati quanto le tecniche di coltura sinora utilizzate.
Test di resistenza ai farmaci standard
Inoltre, l’analisi molecolare rende possibile per la prima volta, rilevare anche i micobatteri tubercolari direttamente dal campione del paziente entro poche ore. Ciò significa che le misure terapeutiche adatte al paziente,possono essere avviate molto più rapidamente. Al contrario, se il paziente ha una infezione tubercolare, un ulteriore test molecolare è effettuato per verificare la sensibilità ai principali farmaci per la tubercolosi, la “rifampicina” e “isoniazide”.
“Questo metodo molecolare predice attendibilmente i risultati di resistenza coltura-based. È possibile avere la certezza, in tempi rapidi, che la terapia con farmaci standard prescelta potrà avere successo”, spiega Keller.
Fonte: University of Zurich